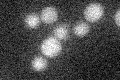
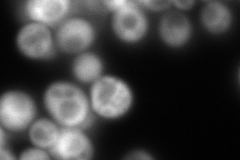

View description
ATPase of the ATP-binding cassette (ABC) family involved in 40S and 60S ribosome biogenesis, has similarity to Gcn20p; shuttles from nucleus to cytoplasm, physically interacts with Tif6p, Lsg1p
Localization:
Intensity:
Fold change:
Significance:
-
C’ GFP library in SD
below threshold15.63 -
N' NOP1pr-GFP in SD

cytosol311.141 -
N' TEF2pr-mCherry in SD
cell periphery,vacuole348.276 -
N' NATIVEpr-GFP in SD

cytosol178.724 -
N' TEF2pr-VC and Cyto-VN in SD

cytosol89.5127 -
C’ GFP library in SD+DTT

cytosol17.121.09No -
C’ GFP library in SD+H2O2

cytosol16.121.03No -
C’ GFP library in Starvation Media

cytosol18.531.18No -
C’ GFP library on the background of Pup2-DaMP

below threshold -
C’ GFP library on the background of CCT mutant

below threshold17.10711.09438No
